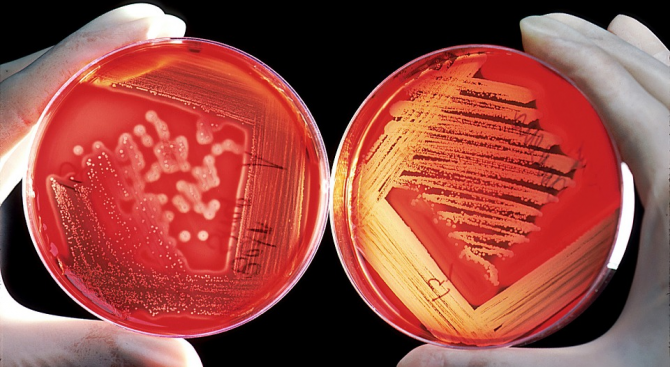
Около 70 процента от микробите на Земята живеят в нейните

... дъската трябва да бъде подменена. В тези увредени участъци се натрупват остатъци от храна и бактерии, които са невъзможни за пълно отстраняване при стандартно миене.
Микробите - Новини
България е успяла да намали употребата на антибиотици в резултат
...... вътреболнични инфекции, но има още много наредби. Нямаме адекватна наредба, с която да се оптимизира изписването на антибиотици в извънболничната помощ", посочи доцент Иван Иванов. FaceBookTwitterPinterest
Учените твърдят че най накрая са разгадали кода зад перфектния шоколадов
...... 29.08.2025 2 28527 12:15 29.08.2025 0 24684 12:16 01.09.2025 0 24116 19:00 29.08.2025 2 28527 10:11 30.08.2025 2 2209
Ново изследване разкрива скритата заплаха от микробите в студените водиАрктическите
...... затопля, арктическите езера не само ще зеленеят, но и ще "говорят" - с езика на метана, който може да окаже значително въздействие върху глобалния климат.
На пръв поглед Карстен Тем е просто още един учен
...... ако микробите в царевичното поле в Калифорния са само началото, бъдещето може да принадлежи не на борбата между човека и природата, а на тяхното обединение.
Ново проучване предполага Химикали от нашето тяло след проучване на
...... по -специално тяхното въздействие върху човешкото здраве, това се отнася до това, че се прави толкова малко за премахването им от нашите тела", каза Патил.
Облаците са наши спътници за цял живот Понякога те се
...... при по-високи температури, отколкото обикновено. Докато ледът разпуква листата, бактериите могат да се хранят с хранителните вещества вътре.5️⃣ Microbes Are in the Air You Breathe
Разпространението на менингококова инфекция е повсеместно но това е заболяване
...... "Не е нужно менингококова ваксина да бъде задължителна, не е нужно да бъде за всички, но би трябвало най-малкото да я има,“ категоричен е той.
Разпространението на менингококова инфекция е повсеместно но това е заболяване
...... е нужно менингококова ваксина да бъде задължителна, не е нужно да бъде за всички, но би трябвало най-малкото да я има,“ категоричен е той.Агенция Фокус
Разпространението на менингококова инфекция е повсеместно но това е заболяване
...... "Не е нужно менингококова ваксина да бъде задължителна, не е нужно да бъде за всички, но би трябвало най-малкото да я има,“ категоричен е той.
Има риск микробите в дихателните пътища на папата да навлязат
...... уговорката, че когато го направи, неговите хронични респираторни проблеми ще останат.Последвайте ни за още актуални новини в Google News ShowcaseПоследвайте btvnovinite.bg във VIBERПоследвайте btvnovinite.bg в INSTAGRAMПоследвайте btvnovinite.bg във FACEBOOKПоследвайте btvnovinite.bg в TIKTOK
Бактериите които живеят в устата ви могат да повлияят не
...... по-добри когнитивни резултати при лица с ЛКН, както и при здрави възрастни хора“, заключават Льоро и нейният екип. Изследването е публикувано в PNAS Nexus. Източник: Science Alert
Първият задълбочен глобален анализ на антимикробната резистентност АМР прогнозира над
...... двамата изследователи, „агитирането за отговорна употреба на антибиотици определено е начин, по който ние като хора можем да помогнем в борбата с АМР.“
Доста стари антибиотици много ефективни бяха забравени поради много ниската
...... им използване дори и най-масовите резистентни микроби от среден приоритет - стрептококи, пневмококи, може да се компенсира с високата им чувствителност към други лекарствени средства".
Къщата само изглежда безопасна защото учените са открили че повече
...... Ежеседмично се препоръчва измиване на подове с почистващ препарат, обработка на водопроводни инсталации, пране на спално бельо, кърпи и парцали за многократна употреба, пише actualno.com.
Астронавтите Трейси Дайсън и Майк Барат отвориха люка към въздушния
...... ново проучване на НАСА има за цел да изследва дали МКС освобождава микроорганизми и ако е така, колко и на какво разстояние могат да пътуват.
Има належаща нужда от нови и иновативни антимикробни лекарствени средства
...... оповести своя първи доклад, в който да призове, че разликите между половете при лечение и търсене на лекарска помощ трябва да бъдат признати от държавите.
Пренасяните по вода микроби могат да живеят и да растат
...... имунна система е отслабена поради рак, трансплантация на орган или ХИВ)Хора със съпътстващи заболявания като диабет, бъбречна недостатъчност или чернодробна недостатъчност Бебета под 6 месецаdariknews.bg
Пренасяните по вода микроби могат да живеят и да растат
...... бъбречна недостатъчност или чернодробна недостатъчност Бебета под 6 месецаВсеки момент е важен! Последвайте ни в и , за да сте в крак с темите на деня
Когато става въпрос за най мръсното място в къщата много хора
...... откриват опасни бактерии по дръжката на хладилника: повечето хора не се замислят много какво пипаме, когато приготвяме храна.Не пропускайте най-важните новини - последвайте ни в
Екип от изследователи от Университета Макгил и Tattoo Lounge MTL
...... метален шип - има доказано въздействие върху екологията на местния кожен микробиом", заключават те. Статията е публикувана в списание Proceedings of the Royal Society B. Източник: IFLScience
Вдъхновете се от седмичен обзор за това да живеете добре
...... хак. Имам едни топли чехли точно пред входната врата – много други култури също го правят“, каза той. „Отидете във всяко азиатско домакинство или дори
Бактерии и гъбички могат да бъдат открити в и около
...... стане също толкова важно, колкото преследването на самите ракови клетки, което води до по-ранни диагнози и дори нови лечения. Но тази работа едва сега започна.
Когато стъпим върху някои неща те се смачкват и сплескват
...... открай време са вдъхновени от този метод и се опитват да направят повърхности с иглообразни структури, които да убиват бактериите по подобен начин.
Дефицитът на имуноглобулин А IgA е най разпространеният първичен имунен дефицит
...... други целеви тъкани и да определят дали тези резултати могат да се използват за прогнозиране на хода на заболяването и резултатите от него." Източник: Medical Xpress
В последно време плуването в дивата природа стана много популярно
...... безопасност.Може би в такъв случай управляваният плувен басейн на открито предлага най-доброто от двата свята - плуване със слънце на гърба в хигиенична среда. Източник: CNN
Доказано е че микробите загиват при наличието на мед тъй
...... топла вода с разтворен в нея 1-2 супени лъжици мед. При първоначален слаб ефект или при събуждане нощем може да се добави още една лъжица.
Микроби от отпечатъка на 8 годишно момче след игра навън Таша Стърм
...... характеристики. Микробите с и без защитни мембрани или камшичета (които им позволяват да плуват) всички те създават колонии с различни цветове, форми, текстури и размери.
Учени смятат че някои от проблемите с физическото и дори
...... хиляди години, е довело до широко разпространение на съвременни проблеми като затлъстяване, астма, псориазис, възпалителни заболявания на червата и дори, според Джилингс, някои психични разстройства.
Свидетели сме на невероятни научни открития идващи от различни краища
...... нови микроби и бактерии и да разберат дали те предизвикват определени конкретни заболявания, това ще отвори просто нова глава в този вид изследвания“, казва Куейк.
Прахосмукачка Независимо колко е забързано ежедневието ви когато вземете прахосмукачката Не
...... 83% от тях имат плесен върху това гумено уплътнение. За да предотвратите образуването му, търкайте гуменета част с разредена белина или специален дезинфектант веднъж седмично.
Намесата на антибиотици може да промени състава на микроби в
...... с наднорменото тегло и се надяват, че изучавайки ролята на микробите в организма ще намерят начин за справянето с този толкова стар и опасен проблем.
ДНК изследване показва че нашите тела съдържат много по богато разнообразие
...... тъй като лещите, с които хората изследваха микробната вселена, бяха много ограничени“, заяви проф. Куейк, имайки предвид, че твърде специализираните изследвания често пропускат голямата картина.
Ново откриване откри че някои патогени успешно нарушават законите на
...... – например във ферма – може да доведе до антибиотична резистентност на друго място, където гените могат да се доведат до нови, опасни комбинации.“ Източник: IFLScience
Опустошителният ефект който човечеството има върху планетата е очевиден Ново
...... потенциално решение за пластмаса в околната среда, също така е мрачно, че микробите са се развили само поради това колко много сме замърсили планетата. Източник: Futurism
С атрактивния Танц на микробите децата от ДГ Валентина ще
...... „Култура, археология и туризъм“ - Пламен Панов, кметът на район „Централен“ - Георги Стаменов и директорът на Регионален исторически музей – Пловдив - Стоян Иванов.
Бактериите и гъбичките могат да обединят усилия за да всеят
...... стохастичен механизъм за мобилност, използван от междувидовите колонизатори, за да се стимулира разширяването на ареала или евентуално навигационна стратегия към желана посока или място." /БГНЕС
Микробите еволюират така че да могат да изяждат замърсяването от
...... решение за пластмасата в околната среда, е тъжно, че микробите се променят заради начина, по който замърсяваме планетата.А тук ще намерите още новини от !
Mикробите в океаните и почвите по света са започнали да
...... че тези молекули разграждат пластмасите по неизвестни досега начини. ООН: Употребата на пластмаса в селското стопанство застрашава безопасността на храните И потенциално здравето на хората
Смятате че къщата ви е чиста Въпреки всички положени усилия
...... ден и да използваме почистващи препарати, специално предназначени за кухня. Тези мерки намаляват също риска от и вирусни инфекции каквито са грипът и настинките например.
Разбирането на микробите тези малки организми може да
...... скоро ще осъзнаем и ще коригираме пренебрежението си и ще издигнем отношението си към многообразието на микробния живот до друго ниво", каза Аусубел.По публикацията работи:
Разбирането на тези малки организми може да бъде
...... Може би скоро ще осъзнаем и ще коригираме пренебрежението си и ще издигнем отношението си към многообразието на микробния живот до друго ниво“, каза Аусубел.
Японски фирми разработиха тъкан която може да произвежда електричество при
...... и срещу новия коронавирус Covid-19. Тестването на това обаче се оказва предизвикателство, тъй като работа с този вирус е разрешена само на ограничен брой институции.
Американски молекулярни биолози разработиха алгоритъм който може да изчисли възрастта
...... приблизително по един и същи начин за всички хора, докато животът на бактериите, гъбичките и вирусите в червата зависи от храненето на всеки отделен човек.
Обожаваме музиката на австрийския композитор Волфганг Амадеус Моцарт защото ни
...... си струват, защото им спестяват много повече на ден. Да влезеш в ума на Жокера Исландската композиторка Хилдур Гурнадотир, която стои зад музиката на филма
1057 1098 1074 1089 1077 1084 1077 1089 1090 1077 1089 1090 1074 1077 1085 1086 1078 1077 1083 1072 1085 1080 1077 1085 1072 1074 1089 1077 1082 1080 1095 1086 1074 1077 1082 1077 1076 1072 1085 1072 1087 1088 1072 1074 1080 1076 1086 1084 1072
...... обаче ще ви разкрием един невероятен трик, благодарение на които ще защитите целия си дом от вредни бактерии.Но кои е той ще научите на jenata.blitz.bg
Около 70 процента от микробите на Земята живеят в нейните
...... конструирали модели на екосистемата, която е дълбоко в земните недра и са изчислили приблизително размера на дълбоката биосфера - 2 до 2,3 милиарда кубични километра.
Около 70 процента от микробите на Земята живеят в нейните
...... конструирали модели на екосистемата, която е дълбоко в земните недра и са изчислили приблизително размера на дълбоката биосфера - 2 до 2,3 милиарда кубични километра.
В сезона на вирусните заболявания е задължително да сме една
...... но можем поне да използваме лична кърпа, която да слагаме върху тях, преди да ги използваме. И не бива да пипаме лицето и устата си.





&format=webp)